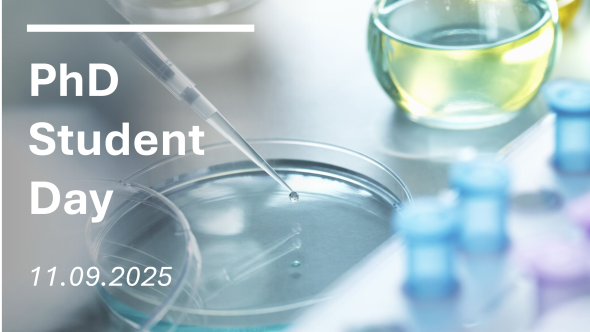
Visuel de l'évènement PhD student day UNamur-UCLouvain

Congrès / Colloque / Conférence
-
Faculté des sciences
Faculté de médecine
Département de biologie
Département de chimie
Département de physique
Département de médecine
Institut Narilis
PhD Student Day - UNamur & UCLouvain
Sciences de la vie et de la santé
Biologie
Chimie
Médecine
11
2025
08:00
-
18:00
Université de Namur, Faculté des sciences, auditoire S01 - rue Grafé, 2 - 5000 Namur
Personne de contact
:
Van Scherpenzeel-Thim Virginie
Cet événement offre une excellente occasion aux doctorants des instituts NARILIS (UNamur) et LIBST (UCLouvain) de présenter leurs recherches, de recevoir des commentaires et de nouer des contacts avec d'autres chercheurs. Les présentations prendront la forme de courtes communications orales ou posters.